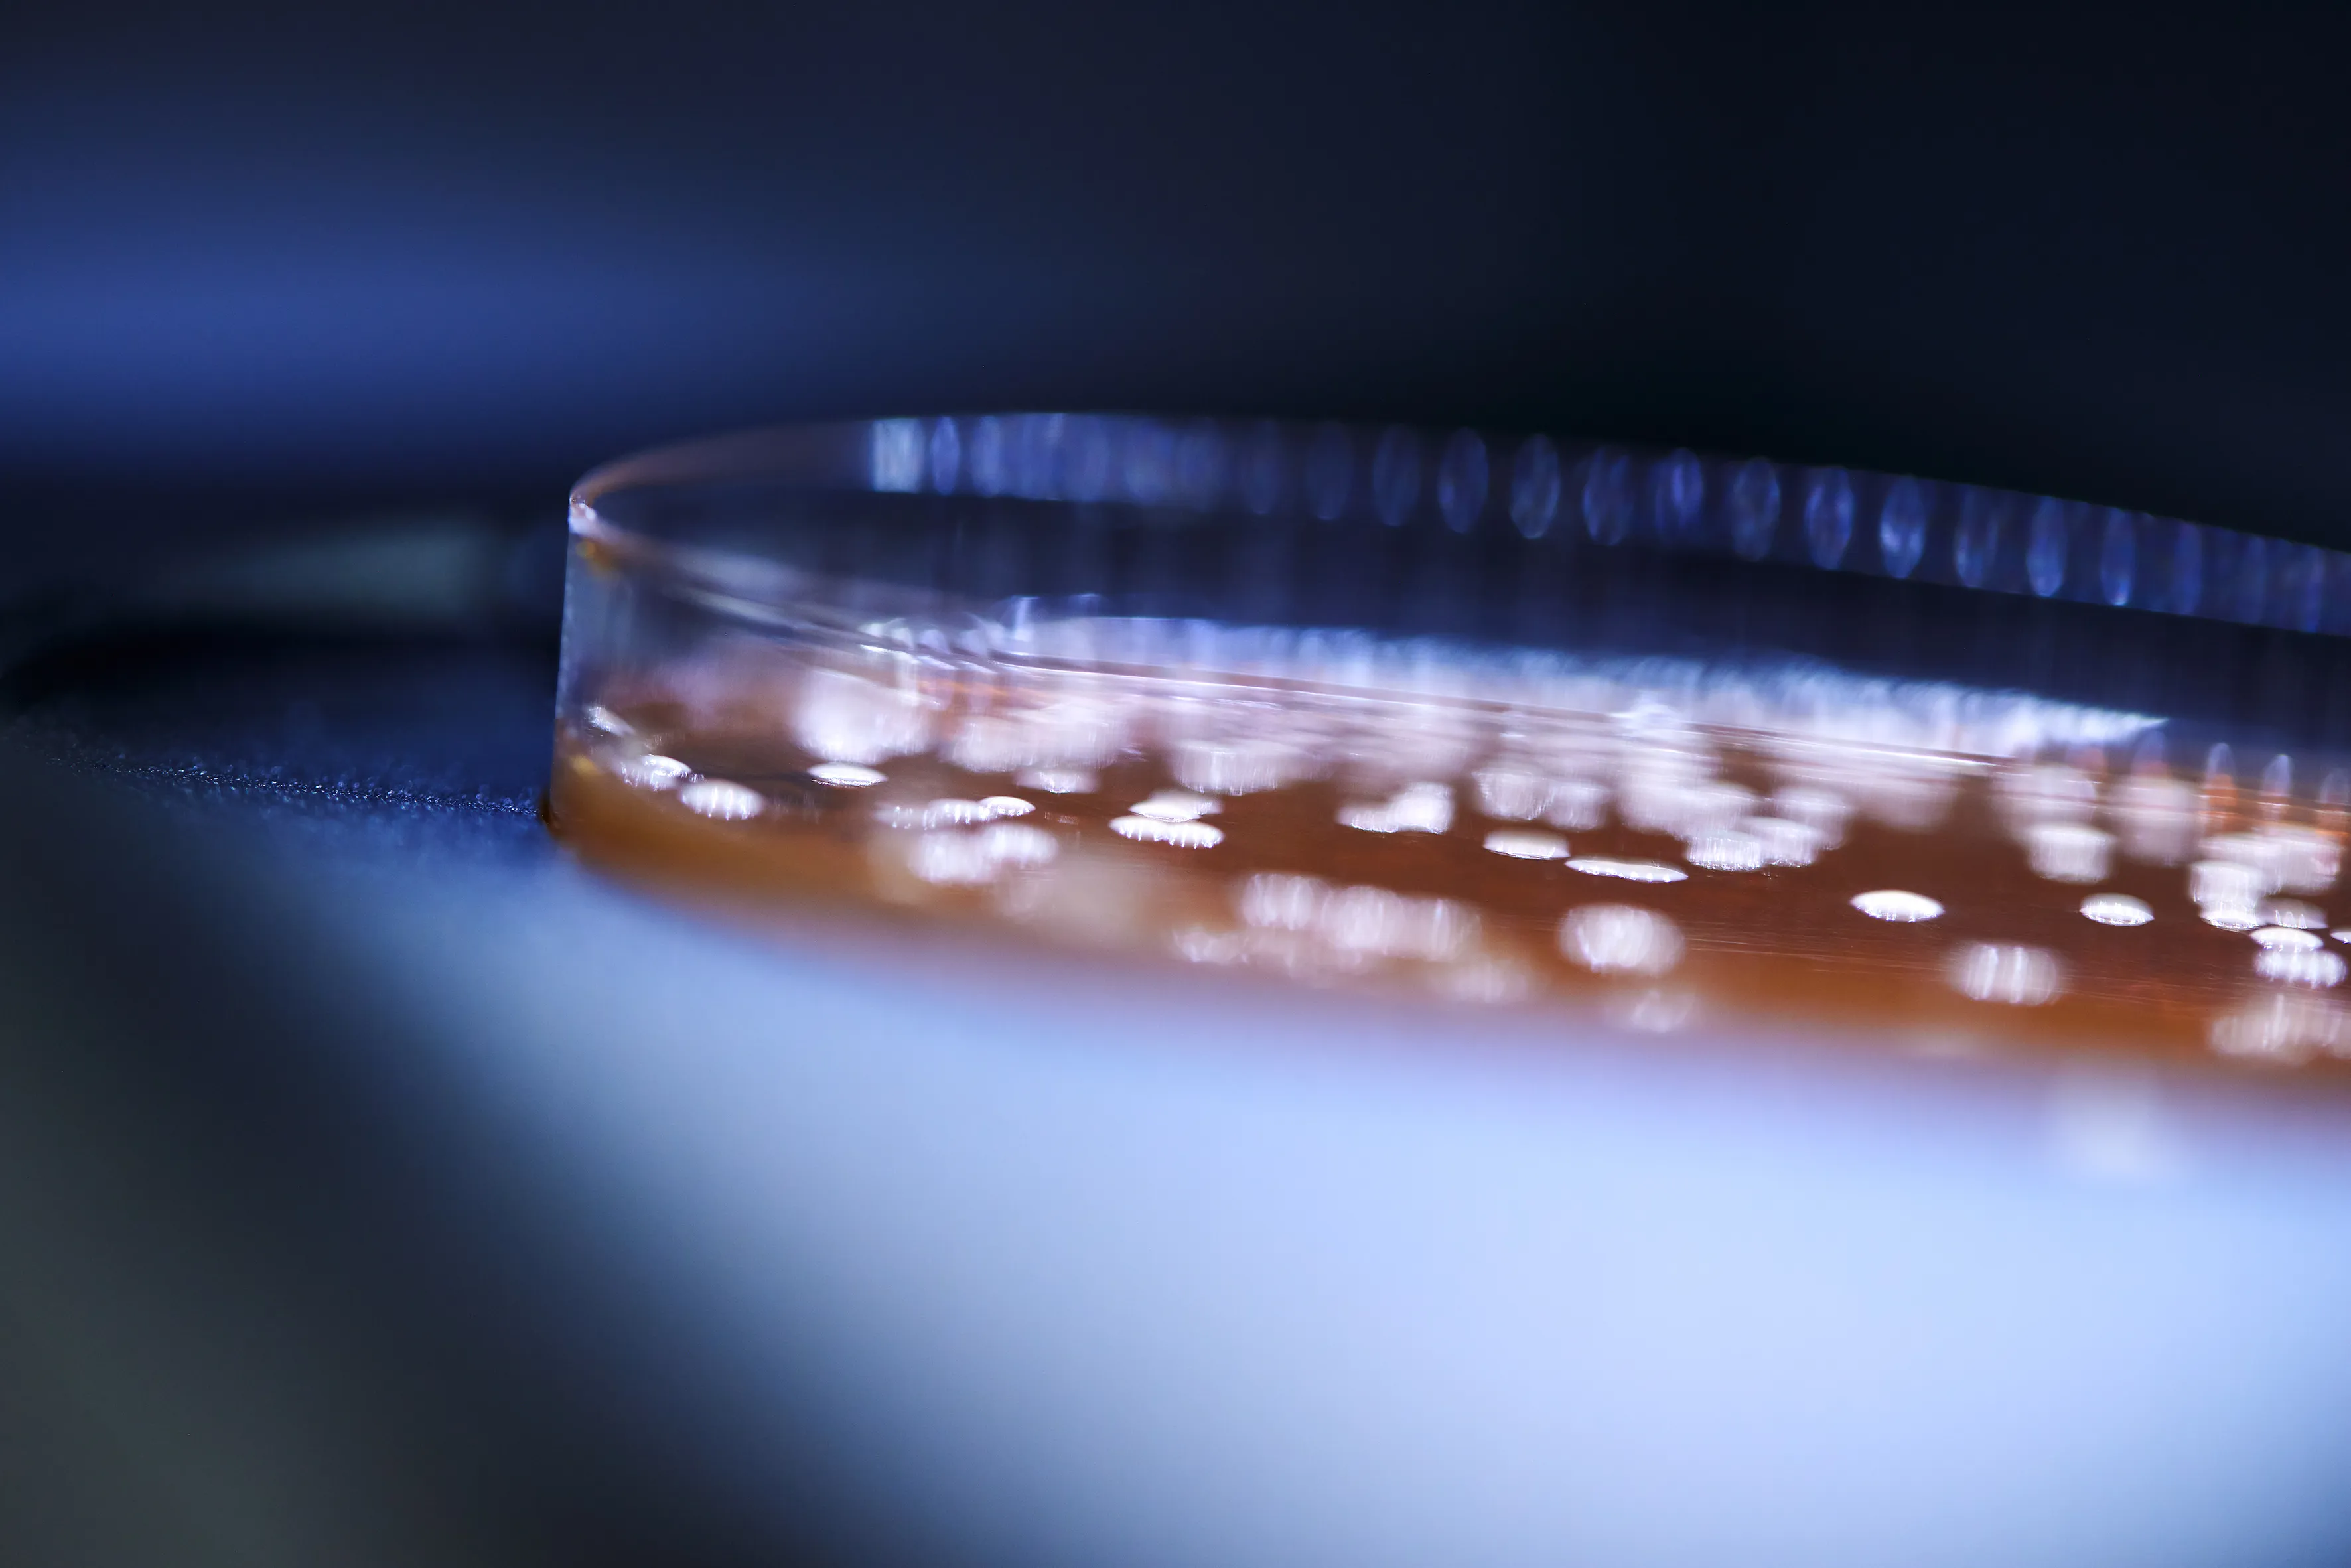
Lab6

Lactiplantibacillus plantarum 299v(LP299V®)の腸内での健康効果は、様々な分野で検証されています。270件を超える科学文献で言及され、80件を超える臨床研究の対象にもなっています。臨床結果は、炎症から代謝の健康に至るまでの幅広い分野で示されています。豊富な文献と臨床エビデンスに裏打ちされているため、この菌株は、消費者のロイヤルティを構築する上で唯一無二で、最適であると言うことができます。

この非常に強靭なプロバイオティクス菌株は、人間の消化管内の過酷な環境に耐えて腸管上皮細胞に付着するため、大きな健康効果を発揮できます。凍結乾燥されたLP299V®菌株は、室温で活性と安定性を維持できるため、カプセル、錠剤、粉末サシェットなどの製品において長期の有効期間を有し、特に食品用やサプリメント向けに適しています。
LP299V®は商標登録されています。この菌株は特許で保護されており、世界中で幅広い適応症および用途向けに承認されています。
*旧称はLactobacillus plantarum 299v
LP299V®ブックレットは、Lactiplantibacillus plantarum 299v菌株の効果を裏付ける科学的な情報をまとめた小冊子です。この菌株がもたらすメリットと広範な研究内容について深く知っていただける機会をご提供します。
このブックレットでは、LP299Vに関するin vitro試験、動物実験、臨床試験の結果を概説しています。また、この菌株の作用の仕組み、結合メカニズム、さらに腸管上皮および粘膜の産生への影響などを取り上げています。
「ブックレットをダウンロード」ボタンのクリックにより、お客様は(i)自身が企業の所属または医療従事者であること、および(ii)この免責事項(利用規約を含む)を読んだ上でその内容を理解して承諾したことを確認したことになります。
just a testing value, ignore this string please